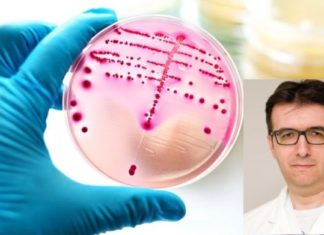
Dr. Martin Ivanovski: Si zbulohen streptokokët dhe pse është e rëndësishme që infeksionet të identifikohen shpejt?

Dr. Martin Ivanovski: Kur kryhet pasqyra e plotë e gjakut?
Shkruan: Dr. Martin Ivanovski
Specialist i biokimisë mjekësore
Për caktimin e statusit të përgjithshëm shëndetësor, për skriningun, diagnozën ose për monitorimin e sëmundjeve të ndryshme dhe gjendjeve që ndikojnë në qelizat e gjakut, siç është anemia,...
Dr. Liljana Tevdovska: Kur dhe pse kryhet EHO-ja e stomakut
Shkruan: Dr. Liljana Tevdovska
interniste
Ekzaminimi me ultratinguj i barkut (EHO e abdomenit) është metodë diagnostikuese që kryhet si tek të rriturit ashtu edhe tek fëmijët, dhe synon të tregojë strukturën e organeve të ndryshme në...
Mr. Spec. Dr. Goran Kolevski: Pse është i rëndësishëm diagnostikimi në kohë i ngushtimit...
Shkruan: Mr. Spec. Dr. Goran Kolevski
Specialist neurolog , subspecialist i neurologjisë vaskulare
Në praktikën e përditshme neurologjike shpesh hasim pacientë që kanë pësuar sulm në tru. Një nga shkaktarët më të zakonshëm të sulmit në...
Dr. Vasko V. Haxhiev: Pse KROMI është i rëndësishëm për metabolizmin e karbohidrateve, lipideve...
Shkruan: Dr. Vasko V. Haxhiev
specialist i mjekësisë interne
Kromi është mineral thelbësor, gjerësisht i pranishëm në natyrë, por në trupin e njeriut janë të pranishme vetëm sasi të vogla. Ashtu si oligoelementët tjerë, në sasi...
Dr. Venco Jovevski: GRIPI – si të ndihmojmë veten
Shkruan: Dr. Venco Jovevski
Mjek i përgjithshëm
Gripi ose influenza është sëmundje virale e shkaktuar nga viruset e acidit ribonukleik (nga familja e viruseve të gripit), që më së shpeshti sulmon zogjtë dhe gjitarët. Megjithatë, gripi...
Ass. Dr. Hristijan Duma: Pse është i rëndësishëm ekzaminimi i rregullt i syve te...
Shkruan: Ass. Dr. Hristijan Duma
Oftalmolog, drejtor i Klinikës së sëmundjeve të syve në Shkup
Diabeti po bëhet epidemi globale dhe është shkaktari i katërt më i zakonshëm i morbiditetit nga sëmundjet jo ngjitëse në botë,...
Dr. Vanço Spirov: Çfarë duhet të bëni kur shfaqet ënjtja te dhëmbët
Shkruan: Dr. Vanço Spirov
Specialist i Kirurgjisë Orale në Qendrën Klinike Dentare “St. Panteleimon ”- Shkup
Dhëmbi është një nga shkaktarët më të zakonshëm të ënjtjes dhe dhimbjes në rajonin orofacial. Bakteret që janë zakonisht të...
Dr. Martin Ivanovski: Si zbulohen streptokokët dhe pse është e rëndësishme që infeksionet të...
Shkruan: Dr. Martin Ivanovski
Specialist i biokimisë mjekësore
Bakteret streptococcus pyogenes, domethënë streptokoket beta hemolitike nga grupi A, është shkaktari më i zakonshëm bakterial i inflamacionit të fytit (faringjit). Streptokoket në fyt zakonisht shfaqen tek fëmijët...
Dr. Vlatko Cvetanovski: Sulmit në tru i paraprijnë shenjat paralajmëruese që zhduken brenda 24...
Shkruan: Dr. Vlatko Cvetanovski
Kirurg kardiovaskular
Sulmi në tru është sëmundje që është gjithnjë e më e zakonshme në raportet dhe statistikat mjekësore, ndërsa sipas vdekshmërisë tashmë është në vendin e tretë, menjëherë pas sëmundjeve të...
Dr. Zlatko Pendovski: Zmadhimi i prostatës mund të jetë pa simptoma për një kohë...
Shkruan: Dr. Zlatko Pendovski
Kirurg-urolog
Pavarësisht faktit që kultura ndaj shëndetit gjithnjë rritet, kur bëhet fjalë për shëndetin e meshkujve, ekzaminimi tek urologu është akoma një temë tabu. Në mjedisin tonë, femrat janë më të disiplinuara...